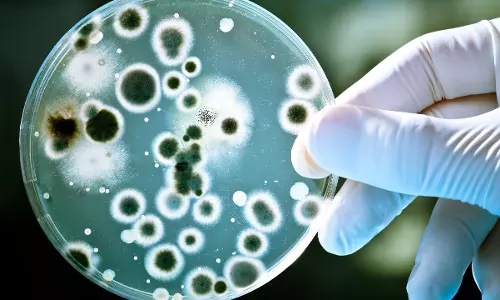
Study warns of high levels of antibiotic-resistant superbugs in Delhi air Study warns of high levels of antibiotic-resistant superbugs in Delhi air

High levels of oral bacteria linked to increased disability in multiple sclerosis patients: study
text_fieldsHigh levels of a bacterium commonly associated with severe gum disease may worsen disability in people living with multiple sclerosis (MS), according to a new study published in Scientific Reports.
Researchers found that elevated levels of Fusobacterium nucleatum — a bacterium linked to periodontitis — were strongly associated with more severe disability among MS patients.
MS is a chronic autoimmune disorder that affects the central nervous system, damaging the protective myelin sheath around nerve cells.
The study showed that nearly 61.5% of MS patients with high levels of Fusobacterium nucleatum experienced moderate to severe disability, compared to only 18.6% among those with lower bacterial levels. This translates to nearly a tenfold increase in the likelihood of severe disability.
“While the gut microbiome has been extensively studied in multiple sclerosis, the role of the oral microbiome has remained largely unexplored,” said Dr. Masahiro Nakamori, associate professor and lecturer at Hiroshima University Hospital. “Because the oral cavity is a major source of chronic inflammation and a potentially modifiable factor, understanding its link to MS severity is crucial.”
The researchers also observed that MS patients who had Fusobacterium nucleatum along with at least one other periodontal pathogen showed even greater levels of disability. Notably, the association was not observed in patients with neuromyelitis optica spectrum disorder or myelin oligodendrocyte glycoprotein antibody-associated disease, suggesting a disease-specific link.
The study proposes that Fusobacterium nucleatum may act as a “bridge bacterium,” connecting oral inflammation with neurological damage. This may help explain how chronic gum disease contributes to systemic inflammation that worsens neurological conditions.
MS is a demyelinating disease in which the immune system attacks nerve insulation, disrupting communication between the brain and the body. While its exact cause remains unknown, factors such as viral infections, smoking, vitamin deficiencies, and genetic susceptibility are believed to play a role.
The researchers emphasized the need for larger, multi-centre studies to confirm their findings and explore whether improving oral health could help slow disease progression in MS patients.